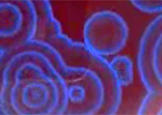

Teaching
Follow the links below for information and materials on my courses. Course descriptions for the bachelor program are in German language, those for the master program are in English.
Bachelorarbeiten
Wenn Sie Ihre Bachelorarbeit in der AG Schalley anfertigen wollen, informieren Sie sich bitte direkt bei den Mitarbeitern der Gruppe über mögliche Projekte, die für Sie von Interesse sein könnten.
Research Internships
For research internships in the Schalley group (master program course no. 21 285a,b), please contact directly the group members who will provide you with details on potential topics of interest.